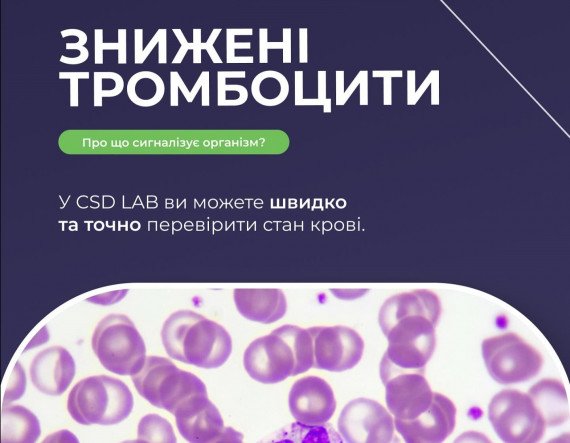

Знижені тромбоцити: про що сигналізує організм?
03.03.2025
Тромбоцити – це формені елементи крові, які беруть участь у процесі згортання крові. Зниження їх може призводити до кровотеч, а підвищення — до тромбозів.
Можливі причини зниженого рівня тромбоцитів (тромбоцитопенії):
- Вірусні інфекції (грип, ГРВІ, COVID-19, гепатит)
- Дефіцит вітаміну B12 або фолієвої кислоти
- Аутоімунні захворювання (червоний вовчак, імунна тромбоцитопенія)
- Онкологічні процеси або побічна дія хімієтерапії
- Захворювання печінки або селезінки
- Вживання певних ліків (антибіотики, протисудомні препарати)
Як розпізнати можливі симптоми?
- Часті синці та кровотечі (з носа, ясен)
- Повільне загоєння ран
- Точкові висипання на шкірі (петехії)
- Надмірна втома та слабкість
Можливі причини підвищеного рівня тромбоцитів (тромбоцитоз):
- Запальні процеси (ревматоїдний артрит, туберкульоз, запальні хвороби кишечника).
- Інфекції (бактеріальні, вірусні або грибкові)
- Онкологічні захворювання
- Крововтрати та анемія (дефіцит заліза стимулює збільшення тромбоцитів)
- Видалення селезінки (приймає участь у регуляції кількості тромбоцитів)
- Фізіологічні фактори (стрес, інтенсивні тренування, післяопераційний період).
Найнебезпечнішим ускладненням тромбоцитозу є тромбоз, ознаками якого є:
- Біль і набряк у кінцівках
- Біль і набряк у кінцівках
- Оніміння та відчуття поколювання в пальцях рук і ніг
- Головний біль, запаморочення
- Порушення зору (відчуття «»мушок»» перед очима, зниження гостроти зору)
- Задишка, біль у грудях
Що робити?
Контроль рівня тромбоцитів – важливий крок для діагностики та попередження серйозних ускладнень. У CSD LAB ви можете швидко та точно перевірити стан крові.
Останні новини